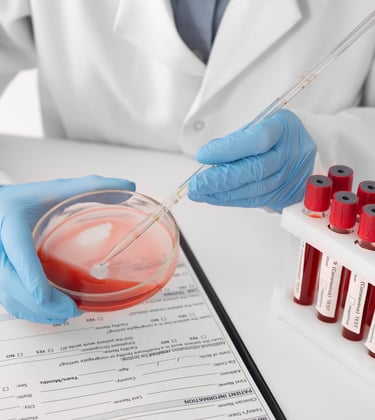

Como funciona?

Consulta completa com análise de couro cabeludo por tricoscopia de luz polarizada para correto diagnóstico
Prescrição de exames laboratoriais para analisar seu metabolismo relacionado a saúde capilar
Elaboração de um protocolo de tratamento específico. Todo protocolo é pautado em literatura científica internacional e comprovado por pesquisas científicas


Quem sou eu?
Biomédica, Dra (Phd) em neurociências pela UNIRIO.
Com 11 publicações científicas em periódicos nacionais e internacionais, ex professora da disciplina de patologia clinica do curso de Medicina da universidade estadual de Mato Grosso- UNEMAT .
Especialista em tricologia clínica com foco em calvície e queda capilar.
“Devido a minha vivência na pesquisa científica e docência , trabalho com protocolos baseados em literatura científica. Garanto que você não sairá da consulta com dúvidas e darei o meu melhor para proporcionar um tratamento adequado para o seu caso”
Localização
Rua Abílio Moreira Miranda 45, 6° Andar, salas 615 Imbetiba, Macaé-RJ.


Edifício Macaé Trade Center














